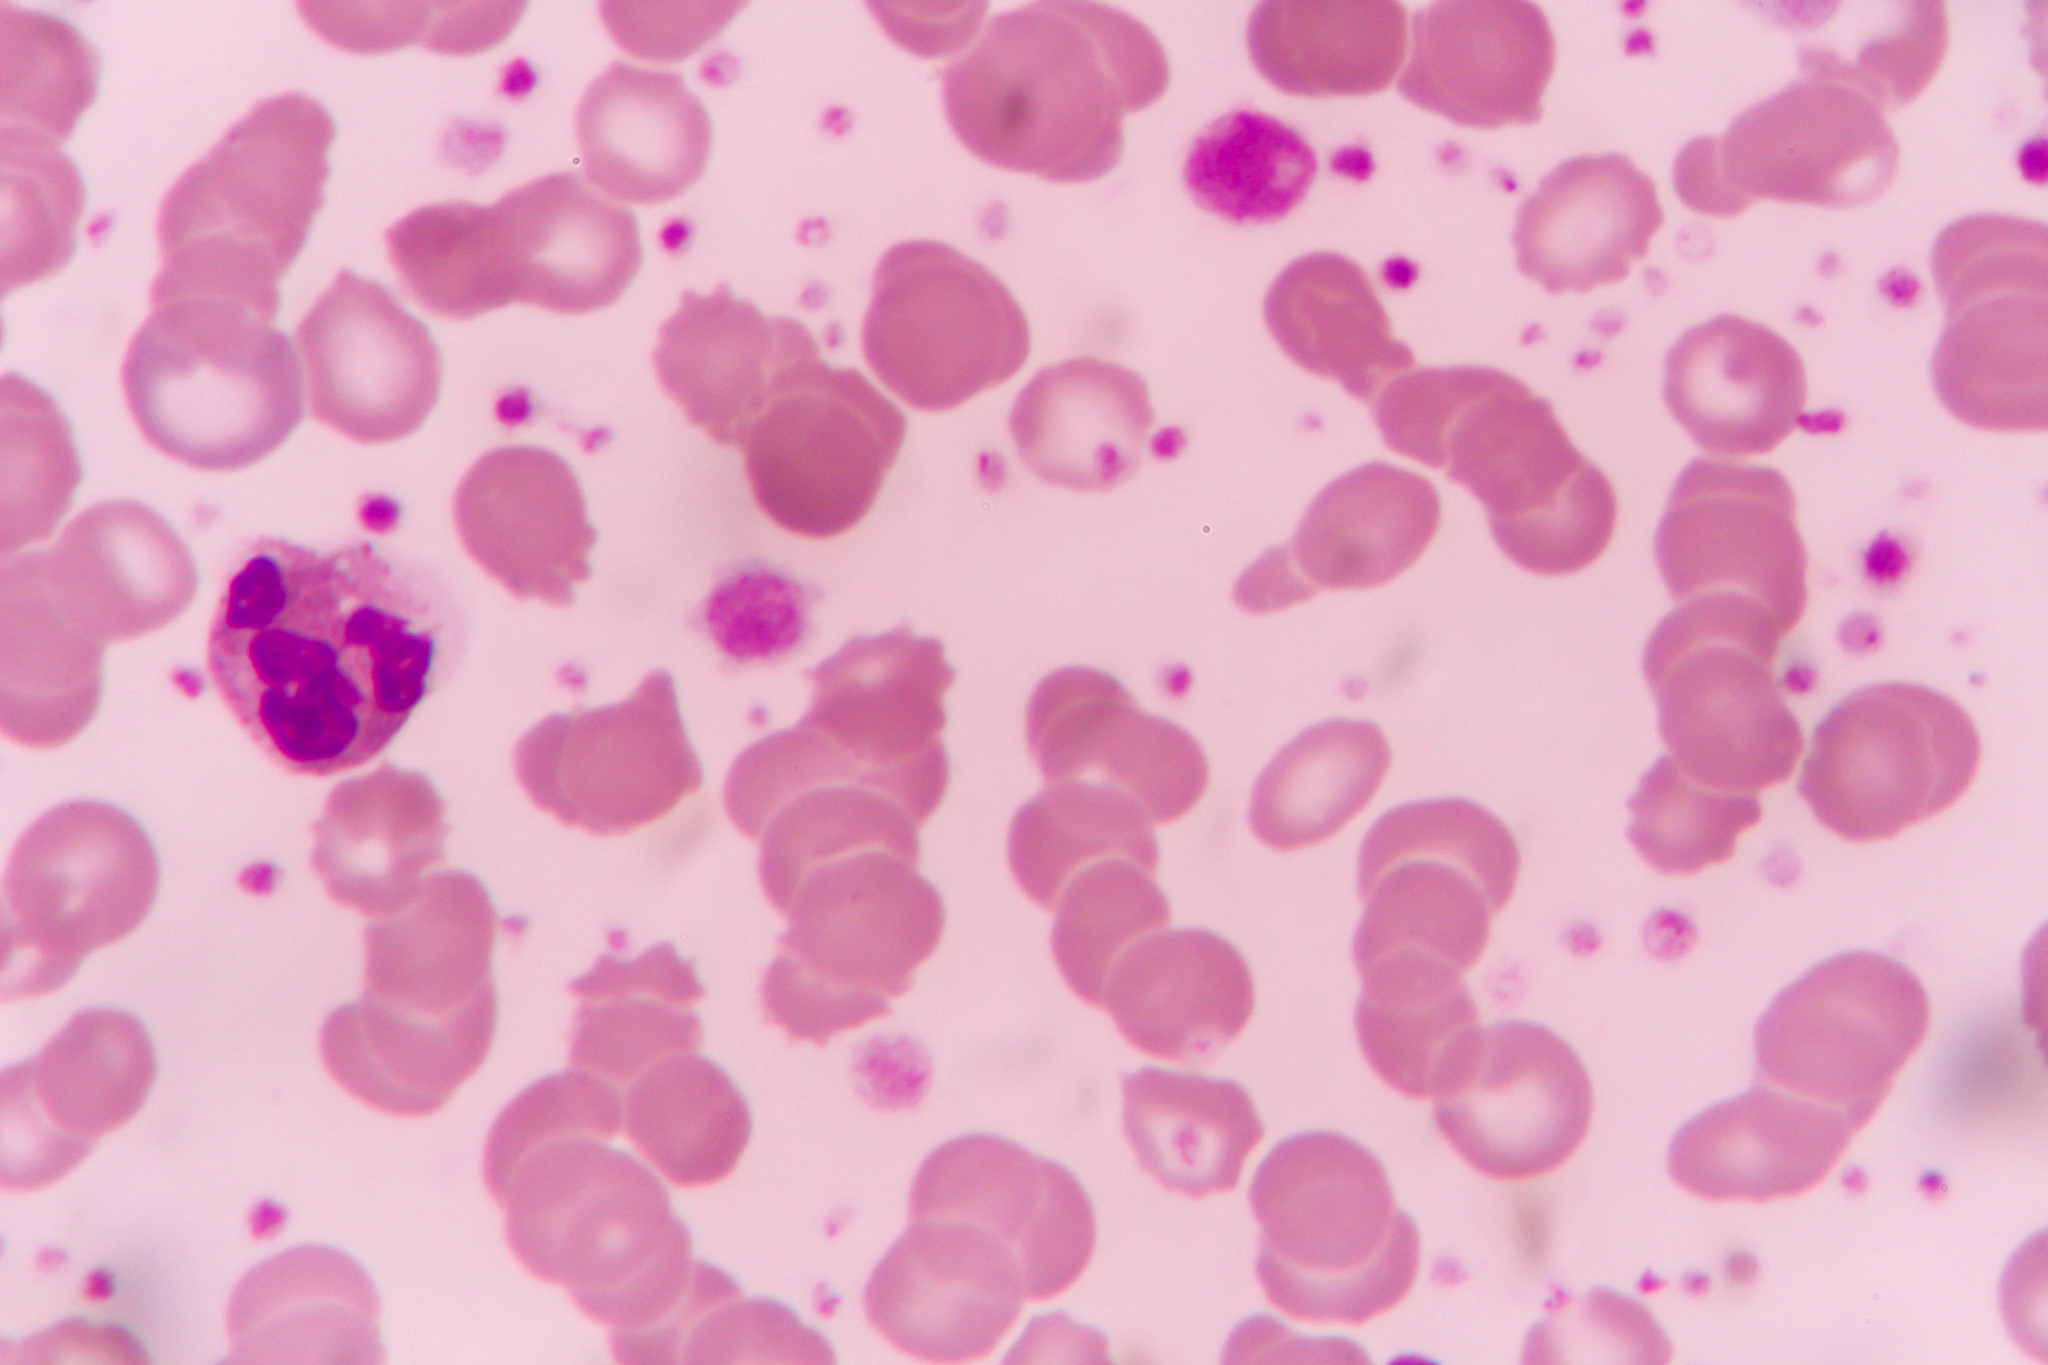
血常规里有哪些指标可以证实可能是病毒感染？

血常规里有哪些指标可以证实可能是病毒感染?
血常规中可能与病毒感染相关的指标包括:
-
白细胞计数:病毒感染时,白细胞计数可能略有增加。
-
中性粒细胞计数:病毒感染时,中性粒细胞计数可能略有增加。
-
淋巴细胞计数:病毒感染时,淋巴细胞计数可能略有减少。
-
C反应蛋白(CRP):病毒感染时,CRP可能轻度升高。
-
血小板计数:某些病毒感染(如登革热)会导致血小板计数下降。
需要注意的是,以上指标仅供参考,病毒感染的诊断还需要综合病史、临床表现、病原学检测等多方面因素进行判断。
原文地址: https://www.cveoy.top/t/topic/53T 著作权归作者所有。请勿转载和采集!